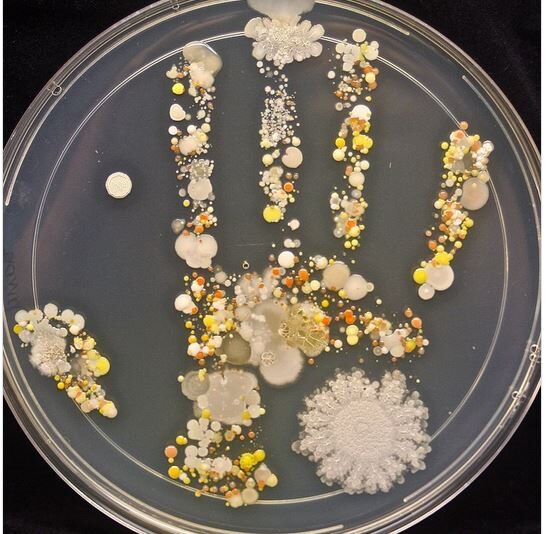

Неверојатен поглед на детската дланка под микроскоп
Дали некогаш сте се запрашале што се има на рацете на вашите деца? Но не само она што го гледате, туку и она што не се гледа со голо око? Еден научник дава одговор на ова прашање.
Поради сите љубопитни родители настана еден таков експеримент! Го извела Таша Струм, мајка и научник, која одлучила да истражи што сè се крие на рацете на нејзиниот осумгодишен син, и тоа после играње во природа и дружење со кучето.
Зела Петриев сад за проучување на разни култури и други микроорганизми и на неа ја притиснала дланката на нејзиниот син. Фотографијата што потоа ја објавила шокира многумина затоа што по неколку дена на неа имало цела палета од бактерии и габички.
– Жолтите и портокаловите дамки се габички, за белите точки се верува дека се бацили – бактерии кои често ги наоѓаме во вода и нечистотија, и стафилококи, бактерии кои можат да бидат причинители на многу инфекции.
И покрај тоа, докторката не се испаничила.
– За мене, тоа е сосема нормално затоа што на тие работи секојдневно сме изложени. Кожата не штити од многу полоши работи. За да имате силен имунолошки систем, мора да бидете изложени на тие работи – порачува таа.
– Габичките не се лоши за здравјето на вашите деца, дезинфекцијата на нивните раце може да направи поголема штета отколку корист, на пр., да се развијат разни алергии. Нивниот имунолошки систем така станува многу чувствителен – вели д-р Џек Гилбер од Универзитетот на Чикаго.
Наместо дезинфекција на рацете, дајте им на своите деца да го користат добриот стар сапун со топла вода.
– Благиот сапун и топлата вода се помалку штетни за целокупното здравје на детето отколку разните дезинфекциски средства – објаснува д-р Гилбер.







